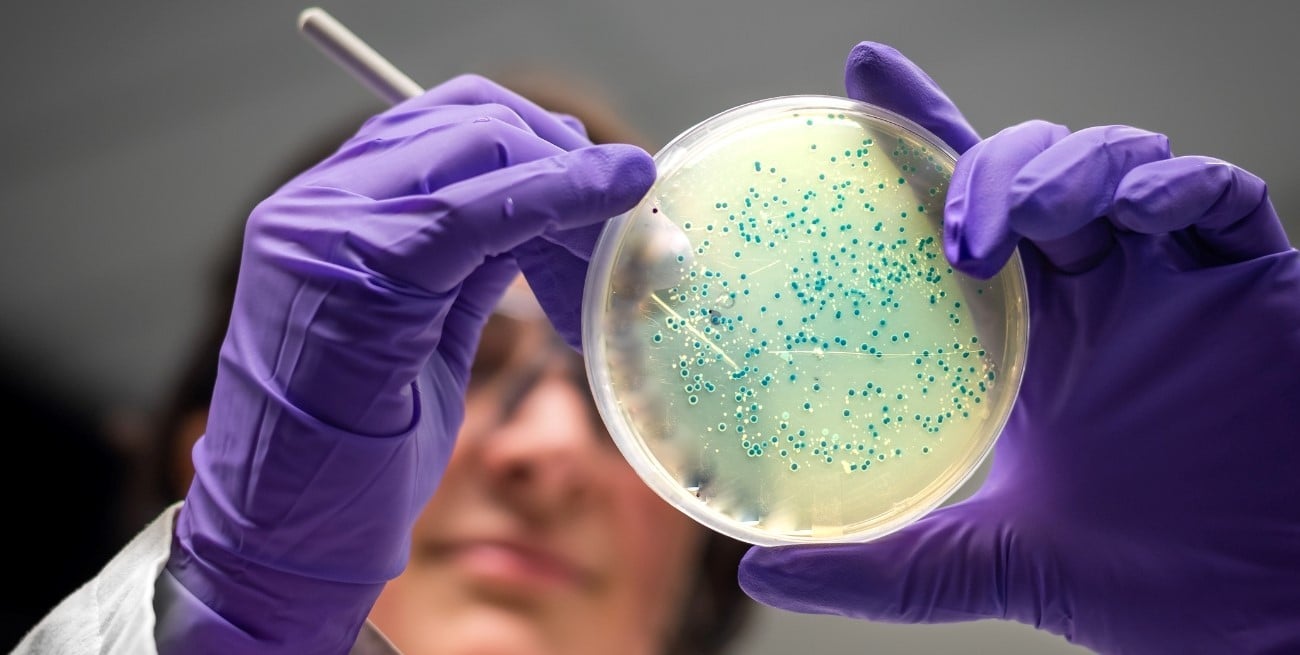
Científicos reactivaron un virus de 48.500 años hallado en Siberia

Un grupo de científicos logró reactivar en laboratorio un virus con una antigüedad estimada de hasta 48.500 años, hallado en muestras de suelo congelado en Siberia. El estudio fue encabezado por Jean-Michel Claverie, de la Universidad de Aix-Marseille, y demuestra que ciertos microorganismos pueden conservar su capacidad infecciosa incluso después de permanecer miles de años inactivos.